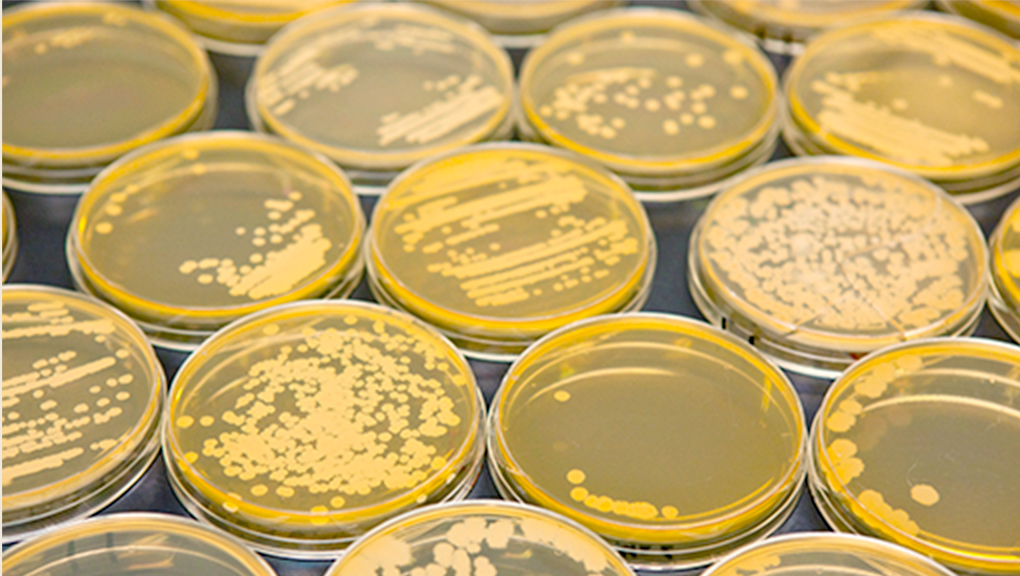

おかめの取り組み
タカノフーズは
「安全でおいしい、食品づくり」を
モットーとして、こだわりを持って
製品づくりに取り組んでいます。
ここでは、タカノフーズの「取り組み」を、
6つのテーマに分けて紹介します。
-
 01
01

お客さまの安心・安全への取り組み
安心・安全な食品をお客さまへお届けするため、徹底した衛生・品質管理を行っています。
詳しく見る -
 02
02

原料大豆の品質管理への取り組み
大豆の選定から倉庫での保管まで、一貫した品質管理を行っています。
詳しく見る -
 03
03

品質の高い原料大豆確保への
取り組み契約栽培による大豆を使い、時間をかけて良質な大豆を選んでいます。
詳しく見る -
 04
04
菌のチカラを生かした納豆づくりへの
取り組み納豆菌を自社で培養・分析し、その性質を知り尽くして製品開発をしています。
詳しく見る -
 05
05

風味の優れた豆腐づくりへの取り組み
原料と製法にこだわることで、風味豊かな豆腐づくりを実現しています。
詳しく見る -
 06
06

おかめマークの変遷
今ではお馴染みのおかめマークは時代と共に、少しずつ変化しています。
詳しく見る

